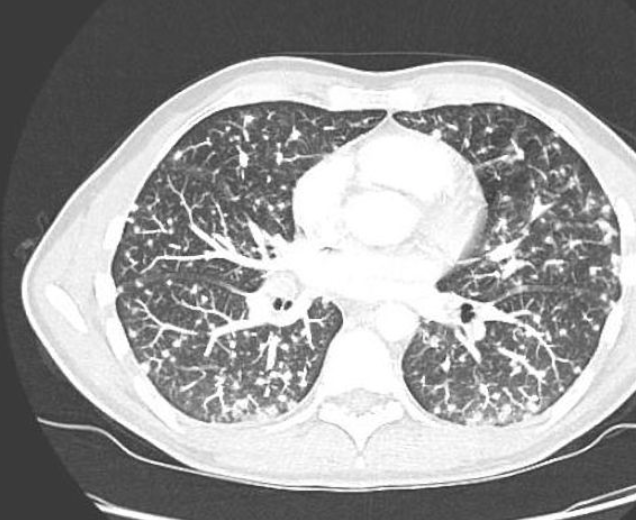
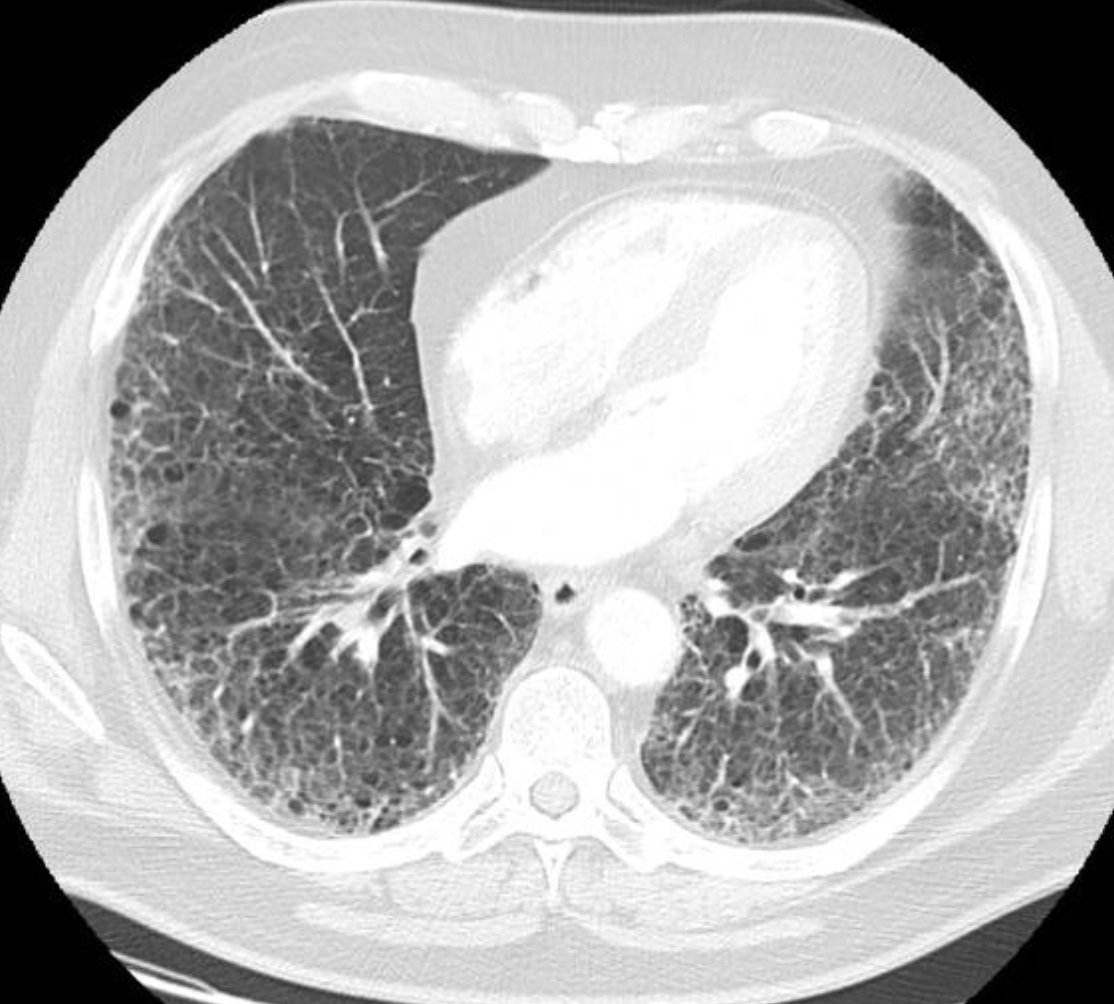

NOCARDIA PNEUMONINA
- Nocardia asteroides
- worldwide distribution
- common opportunistic invader
- lymphoma
- steroid treatment/Transplant patients
- Pulmonary alveolar proteinosis
- Focal consolidation
- cavitation
- irregular nodules
MEDIASTINAL HISTOPLASMOSIS
What does it follow?
Two entities
Rad Features?
- Mediastinal histoplasmosis may follow pulmonary histoplasmosis
- There are two distinct entities that may not always be separable from each other.
- mediastinal granuloma
- results from the spread of H Capsulatum to lymph nodes
- Granulomas usually calcified
- displacement of the superior vena cava or esophagus
- Mediastinal fibrosis (fibrosing or sclerosing mediastinitis
- May cause superior vena cava syndrome, airway compression, PA occlusion, pericarditis.
- Diffuse infiltration of the mediastinum
- Multiple densely calcified nodes.
- mediastinal granuloma
Radiological findigs suggestive of Vasculitis
7
- ulcerating deforming upper a/w lesions
- palpable purpura
- peripherla neuropathy
- rapidly progressive GN
- Pulmonary renal syndrome
- Nodules or cavities
- diffuse alverolar haemorrage
What?
Pulm findings
how to dx
Associations
Types

- INTRO
- Extracellular depositions of protein derived from light chains of monoclonal immunoglobulin
- Classification
- primary
- heart, lung (70%), skin, tongue, nerves
- secondary
- liver, spleen, kidney
- seen in infection, inflammation, neoplasm
- familial
- Mediterranean fever
- localized
- isolated organs
- Aging-associated
- primary
- Xray non-specific
- +/- nodules
- diffuse linear patterns
- Pulmonary involvement can be diffuse or focal
- Bx to dx.
- Case Discussion
- This case illustrates a histologically confirmed focal amyloidosis causing right bronchial encasement. There are also multiple pulmonary nodules, a few of them demonstrating flecks of calcifications, thought to represent nodular pulmonary amyloidosis given the imaging appearances, minimal interval change over time, and confirmed tracheobronchial amyloidosis.
- ASSOCIATIONS
- There is a known association between pulmonary amyloidosis AL type and Sjogren syndrome.
Causes of Calcified Pulmonary metastases
(8)
- Chondrosarcoma
- Treated choriocarcinoma
- Breast ca
- Ovarian ca
- Colon Ca
- GCT
- Synovial Sarcoma
- Thyroid/meddullary thyroid ca
BACTERIAL INFECTIONS
Common pathogens
- S pneumoniae
- Lobar or segmental pneumonia pattern
- bronchopneumonia
- round pneumonia
- myocplasma
- Aerobes
- G-neg bact
- staphyloccus
- bronchopnumonia
- bilateral >60%
- Abscess cavities 25-75%
- Pleural effusion, empyema 50%
- Pneumatoceles (particularly in kids, check valve obstruction)
- Central lines
- signs of endocarditis.
- haemophilus (infants andCOPD)
- pseuodmonas pneumonia
- Hospital acquired infection
- VEntilated patient
- Reduced host resistance
- CF
- 3 main presentations
- extensive bilateral parenchymal consolidation (predilection for lower lobes)
- abscess formation
- diffuse nodule disease. Bacteraemia with hematogenous spread (rare).
- Legionnaires
- Severe pulmonary infection caused by legionella hemophilia, 35% of patients require ventilation, 20% mortality. Most infections are community-acquired. Hyponatremia. Seroconversion takes 2 weeks.
- initial presentation off peripheral patchy consolidation
- bilateral severe disease
- rapidly progressive
- pleural effusions <50%
- LL predilection
- Severe pulmonary infection caused by legionella hemophilia, 35% of patients require ventilation, 20% mortality. Most infections are community-acquired. Hyponatremia. Seroconversion takes 2 weeks.
- H. Influenzae.
- occurs in kids, immunocomp adults or patients with COPD
- Concominant meningitis, epiglotitis and bronchitis.
- Bronchopneumonia pattern
- LL predilection, often difuse
- Empyema
- Mycoplasma pneumonia
- Most common nonbacterial pneumonia (atypical pneumonia). Mild course 5-20 years. Positive for cold agglutinins, 60%
- LL predilection, often diffuse
- reticular
- consolidation 50%.
- Complications
- Autoimmune Haemolytic anaemia
- Erthema nodosum, erythema miltiforme
- SJS
- Meningoencephalitis.
- Klebsiella Pneumonia
- Gram neg organism
- debilitated patients or alcholism
- consolidation appears similar to that of s. pneumoniae
- Lobar expansion
- cavitation, 30-50%. typically multiple
- Massive necrosis (pulmonary gangrene)
- Pleural effusion uncommon.
- TB
- usually requires constant or repeated contact with sputum positive patients because the tubercle does not easily grow in the immunocompetent human host.
- Homelessness
- alcoholics
- Immigrants
- elderly
- AIDS
- Prisoners
- Primary infection
- Usually heals without complications. The sequence of events includes
- Pulmonary consolidation (1-7cm)
- invitation Is rare
- LL 60%, >UL
- caseous necrosis 2-10 weeks after infection
- LAD (hilar and paratracheal) 95%.
- Pleural effusion 10%
- Spread of primary focus occurs primarily in kids or immunosuppressed.
- Usually heals without complications. The sequence of events includes
- Secondary infection
- active disease in adults most commonly represents reactivation of primary focus. However primary disease is now also common in adults in developed countries because there is no exposure in child hood.
- Typically limited to apical and posterior segments of ULs or superior sets of LLs
- Rarely in anterior segments of ULs (in contradistinction to histoplasmosis).
- Exudative TB
- Patchy or confluent air space disease. Adenopathy uncommon.
- Fibrocalcific TB
- Sharply circumscribed linear densities radiating to hilum
- Cavitations
- usually requires constant or repeated contact with sputum positive patients because the tubercle does not easily grow in the immunocompetent human host.
- Complications
- Milary TB (may occur after primary or secondary haematogenous spread.
- Bronchogenic spread occurs after communication of the nectrotic area with a brocnhus, it produces an acinar pattern, irregular nodules approximately 5mm in diameter.
- Tuberculmoa 1-7cm nodule during primary or secondary TB. May contain calcificaiton
- EFFUSIONS are often loculated
- Bronchopleural fistula
- Pneumothorax
Collagen vascular disease in the lungs
intro
pathogenesis
- INTRO
- common pathogenesis in the lung
- immune response
- inflammation (interstitial pattern/granuloma)
- vasculitis
- obstruction
- respiratory insufficiency
- pulmomary artery HTN
- common pathogenesis in the lung
Definition, Rx
ediemiology
prognosis
associations (2)

- Definition
- Multisystem granulomatous disease of unknown cause most commonly effecting the lungs
- Rx
- steroids
- Epid
- more common in blacks
- Prog
- 20% progress to Pulmonary fibrosis
- Associations
- Lofgren syndrome (fever LAD and errythema nodosum)
- Heerfordt sundrome (parotid gland enlargement, fever, uveitis, cranial nerve palsies. )
*
Plain radiograph anatomic Landmarks 2 - Posterior Junction line
four layers of pleura. extends above clavicles and can often be seen on a frontal radiograph ass verticle line traversing the tracheal air column.
What is this condition?
PHASES with HRCT FINDINGS

ACUTE INTERSTITAL PNEUMONIA
- Appears similar to ARDS but often with a symmetric Lower Lobe distribution
- EXUDATIVE PHASE (shown in pic one case)
- GGO
- Consolidation
- ORGANISING PHASE (pic two)
- architectural distortion
- traction bronchiectasis
- Honey combing

TB
PRimary and secondary
complications
- TB usually requires constant or repeated contact with sputum positive patients because the tubercle does not easily grow in the immunocompetent human host.
- Homelessness
- alcoholics
- Immigrants
- elderly
- AIDS
- Prisoners
- Primary infection
- Usually heals without complications. The sequence of events includes
- Pulmonary consolidation (1-7cm)
- cavitation Is rare
- LL 60%, >UL
- caseous necrosis 2-10 weeks after infection
- LAD (hilar and paratracheal) 95%.
- Pleural effusion 10%
- The spread of primary focus occurs primarily in kids or immunosuppressed.
- Secondary infection
- active disease in adults most commonly represents reactivation of primary focus. However the primary disease is now also common in adults in developed countries because there is no exposure in childhood.
- Typically limited to apical and posterior segments of ULs or superior segs of LLs
- Rarely in anterior segments of ULs (in contradistinction to histoplasmosis).
- Exudative TB
- Patchy or confluent air space disease. Adenopathy uncommon.
- Fibrocalcific TB
- Sharply circumscribed linear densities radiating to hilum
- Cavitations
- Complications
- Millary TB (may occur after primary or secondary hematogenous spread.
- Bronchogenic spread occurs after the communication of the necrotic area with a bronchus, it produces an acinar pattern, irregular nodules approximately 5mm in diameter.
- Tuberculmoa 1-7cm nodule during primary or secondary TB. May contain calcification
- EFFUSIONS are often loculated
- Bronchopleural fistula
- Pneumothorax

Lymphomatoid Granulomatosis
Now considered a B-Cell lymphoma
M>F
Multiple small nodules are similar to those of wege4ners
nodules are not numerous and tend to cavitate.
INFECTIOUS CAVITATING LESIONS
- Abscess: necrosis of lung parenchyma +/- bronchial communication
- fungal ball (air crescen/Monad sign)
- Postprimary TB (favour apical and superior segs). Pneumatoceles Causes by air leak into pulmonary interstitium.
- anerobic bacteria
- aspergillus
- m. tubercylosis
- S aureus

S. AUREUS PNEUMONIA
bronchopnumonia
bilateral >60%
Abscess cavities 25-75%
Pleural effusion, empyema 50%
Pneumatoceles (particularly in kids, check valve obstruction)
Central lines
signs of endocarditis.
Upper lobe predominant Conditions
(9)
CASE:
M25 Low-grade fever, cough, shortness of breath with a history of bronchial asthma, eczema at hands and feet, nasal polyposis, and past episode of pericarditis.

- BREASTS
- Beryilosis
- Radiation fibrosis
- Eosinophilic pneumonia, Extrinsic allergic Alveolitis
- Allergic Bronchopulmonary aspergiolosis. Ankylosing Spondylosis
- Sacroid
- TB
- Silicosis
Picture: Typical symtpoms of eosinophilic granulomatosis with polyangiitis are present (e.g. chronic nasal polyposis, past pericarditis and onset respiratory symptoms). Imaging illustrates a ground glass pattern compatible with eosinophilic pneumonia and, in addition to this, laboratory findings (peripheric eosinophilia, BAL with high count of eosinophils) confirm the diagnosis.

Diffuse opacities
- Reticulonodular pattern
- interstitial peribronchial areas of inflammation (viral)
- Alveolar location (PCP)
- Miliary Pattern (TB)
- Viral, Mycoplasma, PCP

Klebsiella Pneumonia
- Klebsiella Pneumonia
- Gram neg organism
debilitated patients or alcholism
* consolidation appears similar to that of s. pneumoniae * Lobar expansion * cavitation, 30-50%. typically multiple * Massive necrosis (pulmonary gangrene)
Pleural effusion uncommon.
What are the
AKA (1),
CLinical presentation (4)
HRCT features (7) and
Histopatholgy (4)
of this condition?

Cryptogenic Organising Pneumonia
- ALSO KNOWN AS
- bronchiolits obliterans organising pneumonia (BOOP)
- CLINICAL PRESENTATION
- Cough
- SOB (mild)
- Fever over several months
- +/- antecedant hx of LRTI/URTI
- HISTOPATHOLGY
- intra-alveolar proliferation of granulation tissue
- temportal uniformity
- similar patttern may be seen in
- collagen vascular disease
- drug exposure/infection
- HRCT findings
- Patchy consolidation/GGO
- Subpleural, peribronchial
- Lower lung > upper
- +/- centrilobular nodules
- +/- large irregularly shaped masses
- ATTOL sign (1st picture) crescent shaped opacity
- REVERSE HALO sign (second picture)
- central GGO with surrouding consolidation.

Ankylosising Spondylitis
Pulmonary findings
7
- pulm fibrosis in 10%
- upper lobe
- scarring
- infiltration
- cystic air spaces
- ossification of spinal ligaments
- sacroilitis
- cardiomegally
VARICELLA ZOSTER PNEUMONIA
- 15% of infected patients have pneumonia
- 90% are older than 20 years.
- ACUTE PHASE
- multiple acinar opacities
- coalescence of acinar opacities to diffuse patchy sad.
- 1-2mm calcifications throughout the lungs after healing
- HRCT usually shows 1-10mm well defined and ill-defined nodules diffusely throughout both lungs
NON TUBERCULOUS MYCOBACTERIAL INECTIONS
NTMB
- Two most common NTMB inffections are M. Avium intracellulae, and M. kansaii
- Unlike TB, NTMB infections are not acquired by human to human transmission, but are a direct infection from soil or water. there is also no pattern of primary disease or reactivation. The infection is primary although some infections may become chronic.
PLASMA CELL GRANULOMA
INTRO
HISTO
EPID
RX
Xray features
- INTRO
- local cellular proliferation of
- spindle cells
- plasma cells
- lymphocytes
- histiocytes
- Most common tumour like pulmonary abnormality in children younger than 15 years
- local cellular proliferation of
- RX resection
- Xray
- solidaty lung mass 1-12 cm
- no or very slow growth
6 forms of pleuropulomonary disease in Rheumatoid Arthitis
Rheumatoid Arthitis
- Rhematoid lung nodules
- necrobiotic
- 20%
- usually multiple
- may change in size rapidly or disapear
- a/w cutaneous nodules
- pleural effsuons/pleuritis
- pleuritis is the most common pulmonary feature of RA
- Caplan syndrome
- nodular rheumatoid lung disease a/w pneumoconiosis fibrosis alveolitis
- Constrictive bronchiolitis
- Lymphoid hyperplasia
- Pulmonary HTN
BRONCHOPNEUMONIA
Primarily affects the bronchi and adjacent alveoli. Volume loss maybe present as bronchi filled with exudates. bronchial spread results in multifocal patchy opacities - S. Aureus - Ve bacteria - Mycoplasma



























































